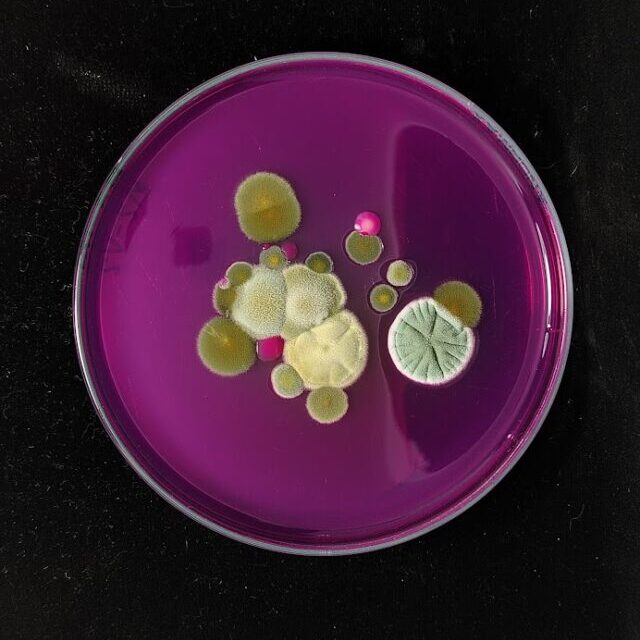

Evaluamos el estado nutricional de las yemas para optimizar el desarrollo de los cultivo.

Detectamos la presencia de nematodos en el suelo y cultivos, ayudando a prevenir daños y mejorar la sanidad vegetal.

Identificamos enfermedades en plantas causadas por hongos, bacterias y virus para aplicar estrategias de control efectivas.

Analizamos la presencia de insectos en los cultivos, determinando su impacto y recomendando medidas de manejo integrado.

Determinamos los niveles de nutrientes en plantas y suelos para optimizar la fertilización y mejorar el rendimiento agrícola.

Realizamos estudios detallados de la flora en áreas agrícolas para mejorar la gestión de cultivos y la biodiversidad.
Evaluamos microorganismos en suelos y plantas para identificar agentes beneficiosos o patógenos que afecten la producción.

Probamos productos biológicos, extractos vegetales y químicos para garantizar su efectividad en el control de plagas y enfermedades.
Obtener un diagnóstico preciso puede ser una de las experiencias más impactantes que pueda tener. 
Copyright Laboratorio Agricola Biaster S.A.C de Seguros 2025. Todos los Derechos Reservados
WhatsApp us